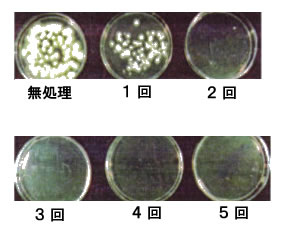

新築・リフォーム工事の(株)大和>食中毒を防ぐ
| YAMATO SSW 主旨 | ||||||||
|
ワサビやカラシのあのツンとくる香りの成分には強い抗菌効果があることが知られています。 この香りの主成分はイソチオシアン酸アリル(AIT) という物質です。 「YAMATO SSW」 は、この AITを微粒子噴霧器により 噴霧・ガス化 させ、より効果的に抗菌処理 できるように製剤化したものです 。 |
||||||||
| 用 途 | ||||||||
| 食品加工場やホテル・旅館・レストランの厨房などで、見えない敵である浮遊菌・落下菌・付着菌の低減。 |
||||||||
| 特 徴 | ||||||||
| (1)成分が全て食品添加物である。 (2)清掃の行き届かない箇所(天井等)も処理が可能 (3)人手をかけない簡便な処理が可能 (4)細菌・カビ・害虫忌避等、幅広い用途に適用可能 (5)イソチオシアン酸アリル(AIT)がガス化しているため噴霧後の什器・備品の後洗浄が不要 (6)イソチオシアン酸アリル(AIT)がガス化しているため食品への混入の問題がない。 |
||||||||
| 効 果(噴霧試験例) 【単回噴霧】 | ||||||||
試験場所: 約200uの事務所
●カビに対する効果 |
||||||||
| 効 果(噴霧試験例)【反復噴霧】 | ||||||||
|
||||||||